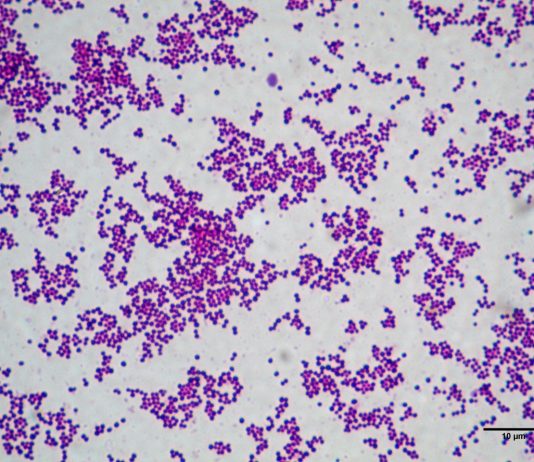

Mô hình răng cắt dọc
Mô hình răng cắt dọc
Cấu trúc giải phẫu của một bộ phận, cơ quan trong cơ thể người cũng như động vật là rất...
MÔ HÌNH NỬA CƠ THỂ
Mô hình nửa cơ thể
Sinh học là một môn khoa học thú vị nghiên cứu về tất cả các thực thể sống có mặt...
Tiêu bản mô động vật và người cho thực hành sinh...
Tiêu bản mô động vật và người
Sinh học là môn khoa học nghiên cứu về sự sống của tất cả các sinh vật trên...
Mô Hình Ếch Cho Học Sinh
Mô Hình Ếch Cho Học Sinh
Sinh học là môn học kỳ thú nghiên cứu về thế giới tất cả các loài sinh vật trên...
Tiêu bản nguyên phân tế bào rễ hành
Tiêu bản nguyên phân tế bào rễ hành
Sinh học mang đến những bài học ly kỳ và thú vị cho các bạn học sinh....
Bộ hoá chất nhuộm HE
Bộ hoá chất nhuộm HE
Để nghiên cứu cấu trúc mô của bất cứ một hệ cơ quan nào trong cơ thể các nhà mô...
Tiêu bản côn trùng
Tiêu bản côn trùng
Trong chương trình lớp 7 các em học sinh sẽ được thầy cô hướng dẫn và tìm hiểu về thế giới...
Mô Hình Hệ Hô Hấp
Mô Hình Hệ Hô Hấp
Sinh học là bộ môn khoa học thực nghiệm, nó rất gần gũi với đời sống hằng ngày của con...
Tiêu bản thực vật
Tiêu bản thực vật
Khi bắt đầu bước vào năm đầu trung học cơ sở, các em học sinh được làm quen với môn sinh...
Tiêu bản vi khuẩn và nấm
Tiêu bản vi khuẩn và nấm
Trong chương trình sinh học lớp sáu, bên cạnh việc học và tìm hiểu về thực vật thì các...